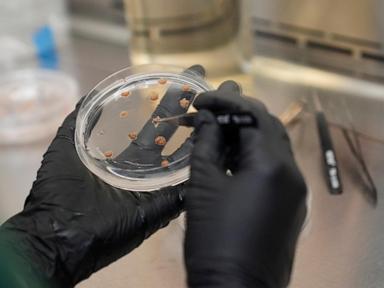
chocolate’s-future-could-hinge-on-success-of-growing-cocoa-not-just-in-the-tropics,-but-in-the-lab

Most teenagers don’t use drugs. There’s data to show that because of a 50-year-old government survey that may now be in jeopardy.
The entire 17-member U.S. government team responsible for the National Survey on Drug Use and Health received layoff notices Tuesday, as part of the overhaul of the U.S. Department of Health and Human Services.
It’s not clear whether there is an alternative plan to analyze the data, which local and state governments use to develop prevention measures and treatment services. The federal government distributes grant money to fight the opioid addiction crisis based on it. Researchers use it to study trends in depression, alcoholism and tobacco use.
An HHS spokesman did not immediately respond to a question about the survey’s future.
The nationally representative survey is conducted in person by an independent research group with about 70,000 people each year. It provides a more complete picture than trends in overdose deaths, which capture only a small segment of the problem, said Lindsey Vuolo of the Partnership to End Addiction.
“We use its findings on a near daily basis in our research, educational programming and resources, and communication materials,” Vuolo said of the survey.
Before the layoffs, the government team was preparing to analyze 2024 data, the first year where trends would be reliable again since the pandemic disrupted data collection, said Jennifer Hoenig, the laid-off director of the Office of Population Surveys.
The data could now sit on the shelf without experienced analysts to untangle it, she said.
“Every person working on it was let go,” Hoenig said, noting that the data collection is mandated by Congress. The office is part of the Substance Abuse and Mental Health Services Administration, which would be absorbed into a new Administration for a Healthy America under Health Secretary Robert F. Kennedy Jr.’s plan.
“My team and I care so much about this data that we want people to understand what is being lost in our country if we don’t have it,” Hoenig said.
In recent years, the survey has found:
— Seven out of 10 adolescents did not use illicit drugs or drink alcohol in 2023.
— Men 60 and older were more likely than women in the same age group to have a substance use disorder, but women were more likely than men to have had a major depressive episode in 2021 and 2022.
— Lesbian, gay and bisexual young people were about twice as likely as straight young people to have had a substance use disorder in 2023.
— People who report using cannabis in the past year nearly doubled over two decades, from 11% in 2002 to 21.9% in 2022.
“In attempting to solve any public health problem, data is critical,” said Andrew Kessler of Slingshot Solutions, a consulting firm that specializes in addiction and mental health issues. “It allows us to advocate for and establish policies that fill very large gaps in treatment, thus saving lives in the process.”
___
The Associated Press Health and Science Department receives support from the Howard Hughes Medical Institute’s Science and Educational Media Group and the Robert Wood Johnson Foundation. The AP is solely responsible for all content.